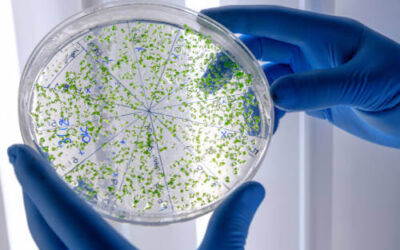
Novedades en la normativa sobre la prevención de la Legionella

Blog
Blog
Últimas noticias y artículos sobre plagas
Enfermedades que transmiten las ratas al ser humano
Los roedores son una de las plagas más molestas que existen. Más allá del rechazo que crean son vectores de transmisión de enfermedades, por lo que...
La plaga de la procesionaria ya está aquí, ¡y todavía estamos en invierno!
Todos los años hacemos referencia a la aparición de la oruga procesionaria y los peligros que supone no solo para para nuestros bosques, sino para...
¿Dónde se esconden las ratas en las casas?
Una de las peores sensaciones que podemos sufrir es pensar que podemos tener una plaga de roedores en casa. Más allá del repelús que dan, es una...
Cuenta atrás para el mayor congreso de empresas de control de plagas
Los próximos 15 y 16 de febrero tendrá lugar una nueva edición de Expocida Iberia. Un congreso, donde a lo largo de estos dos días, el pabellón 10...
Novedades en la normativa sobre la prevención de la Legionella
Desde que el año pasado entrará en vigor el Real decreto 487/2022 referente a la prevención de la Legionella ha habido algunos aspectos de la...
¿Qué atrae a las cucarachas hasta un hogar?
Probablemente las cucarachas sean una de las especies más odiadas. Más allá del repelús o aprensión que transmiten, las empresas de control de...
La importancia de la colaboración ciudadana en el control de plagas
Las empresas de control de plagas siempre hemos dicho que las labores de prevención son la mejor herramienta contra insectos y roedores. Actuar...
Localizan por primera vez un insecto que es considerado una plaga de la madera en China
Si uno de los problemas más comunes que tienen las empresas de control de plagas tienen que ver con las termitas y los tratamientos de la madera,...
¿Cómo dar con los nidos de cucarachas?
Junto con las ratas, quizás las cucarachas sean una de las plagas más habituales en viviendas y/o locales comerciales. La falta de una labores de...
El Ayuntamiento de Getxo decide poner freno a la plaga de gaviotas
El Ayuntamiento de Getxo ha decidido poner freno al incremento de la presencia de gaviotas en sus calles. Como si fuera una empresa de control de...